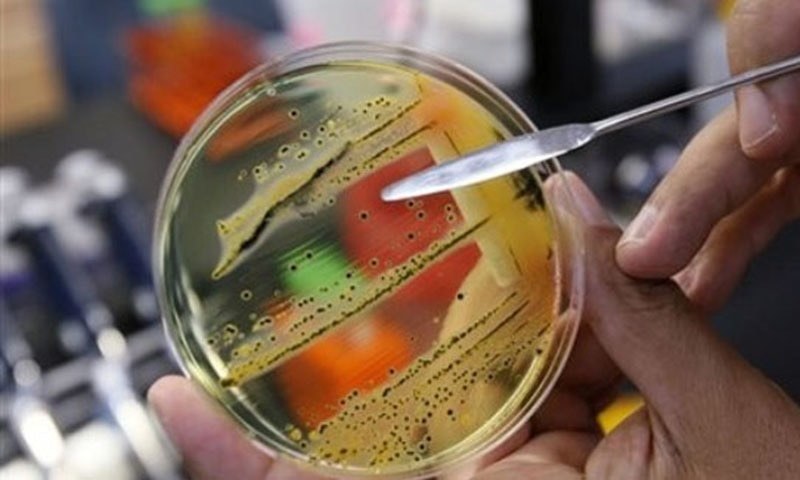
Pakistani population has high antimicrobial resistance levels: study

Pakistani population has high antimicrobial resistance levels: study
- By Web Desk -
- Mar 20, 2019
A comprehensive analysis of sewage collected from 74 cities in 60 countries has revealed that Pakistan has high antimicrobial resistance (AMR) in healthy population.
It was for the first time that genetic material in raw sewage samples were assessed to check AMR levels. Titled ‘Global monitoring of antimicrobial resistance based on metagenomics analyses of urban sewage’, the research yielded the first comparable global data on AMR in healthy population.
Scientists categorised participating countries in two groups; North America, Western Europe, Australia and New Zealand, which generally have the lowest AMR levels whereas Asia, Africa and South America have the highest levels.
According to findings, the Netherlands, New Zealand and Sweden have the lowest levels of resistance, whereas Tanzania, Vietnam and Nigeria have the highest levels.
Other countries with highest estimated AMR levels include Pakistan, Afghanistan and Bangladesh in South Asia, and Kenya and Uganda in East Africa.
The research is led by the National Food Institute at the Technical University of Denmark and conducted by an international team of scientists including Drs Rumina Hasan and Sadia Shakoor from the department of pathology and laboratory medicine at the Aga Khan University (AKU).
The research paper is published in the Nature Communications journal.